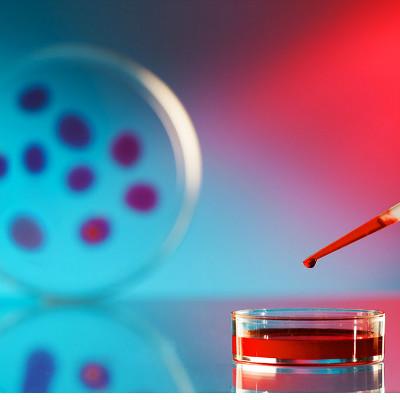

Why do you have myelitis?
summary
Myelitis is undoubtedly caused by various bacteria and viruses that invade the spinal cord. Of course, it is serious, and it is also a very common disease. This disease is mainly caused by bacteria, viruses and parasites. When suffering from this disease, we must check and treat it in time, The earlier the disease is found, the more obvious the effect of treatment will be. When suffering from this disease, if not treated in time, it will seriously affect the normal life of patients. During the treatment of this disease, we must pay attention to a reasonable diet. During the treatment, a reasonable diet is also very important. Let's take a look at the following.
Why do you have myelitis?
First: when suffering from this disease, the symptoms of different patients are not the same. Some patients will have respiratory tract infection when suffering from this disease, because this disease is mainly caused by the infection of bacteria, so the emergence of respiratory tract infection is also a very common situation.
Second: the patients must be treated in time when they have this disease, and the main treatment of this disease is drug treatment. As long as the disease is treated in time, the situation will still improve, but during the treatment, they must insist on taking drugs, so as not to affect the treatment results.

Third: if the situation of myelitis is serious, it will have a serious impact on patients. Sometimes this disease will lead to paralysis or urinary incontinence, so we must pay more attention to it in peacetime, and we must check and treat it in time.

matters needing attention
When suffering from this disease, we must eat more nutritious food. At the same time, the patients must keep warm every day and have enough sleep every day.














